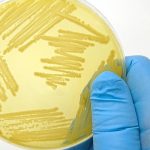
Doença de Parkinson

O valor vital do leite materno para os bebês

Fundamental para a formação da microbiota

Zinco e LcS no perfil lipídico de mulheres obesas

Bacteriófagos são inimigos mortais de bactérias

Cirrose pode levar à falência total do fígado

Jabuticaba é gigante em benefícios
Influência de fungos no Parkinson

O poder farejador dos cães

Parceria com a natação

Tonyu celebra 40 anos de mercado